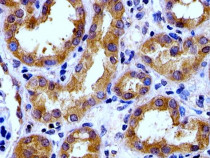

ARG55846
anti-SPHK1 antibody
anti-SPHK1 antibody for IHC-Formalin-fixed paraffin-embedded sections,Western blot and Human,Mouse
Overview
| Product Description | Rabbit Polyclonal antibody recognizes SPHK1 |
|---|---|
| Tested Reactivity | Hu, Ms |
| Tested Application | IHC-P, WB |
| Host | Rabbit |
| Clonality | Polyclonal |
| Isotype | IgG |
| Target Name | SPHK1 |
| Antigen Species | Human |
| Immunogen | KLH-conjugated synthetic peptide corresponding to aa. 59-89 (N-terminus) of Human SPHK1. |
| Conjugation | Un-conjugated |
| Alternate Names | SK 1; SPK 1; EC 2.7.1.91; SPHK; Sphingosine kinase 1 |
Application Instructions
| Application Suggestion |
|
||||||
|---|---|---|---|---|---|---|---|
| Application Note | * The dilutions indicate recommended starting dilutions and the optimal dilutions or concentrations should be determined by the scientist. | ||||||
| Positive Control | Human kidney |
Properties
| Form | Liquid |
|---|---|
| Purification | This antibody is prepared by Saturated Ammonium Sulfate (SAS) precipitation followed by dialysis against PBS. |
| Buffer | PBS and 0.09% (W/V) Sodium azide |
| Preservative | 0.09% (W/V) Sodium azide |
| Storage Instruction | For continuous use, store undiluted antibody at 2-8°C for up to a week. For long-term storage, aliquot and store at -20°C or below. Storage in frost free freezers is not recommended. Avoid repeated freeze/thaw cycles. Suggest spin the vial prior to opening. The antibody solution should be gently mixed before use. |
| Note | For laboratory research only, not for drug, diagnostic or other use. |
Bioinformation
| Database Links | |
|---|---|
| Gene Symbol | SPHK1 |
| Gene Full Name | sphingosine kinase 1 |
| Background | The protein encoded by this gene catalyzes the phosphorylation of sphingosine to form sphingosine-1-phosphate (S1P), a lipid mediator with both intra- and extracellular functions. Intracellularly, S1P regulates proliferation and survival, and extracellularly, it is a ligand for cell surface G protein-coupled receptors. This protein, and its product S1P, play a key role in TNF-alpha signaling and the NF-kappa-B activation pathway important in inflammatory, antiapoptotic, and immune processes. Alternatively spliced transcript variants encoding different isoforms have been found for this gene. [provided by RefSeq, Sep 2011] |
| Function | Catalyzes the phosphorylation of sphingosine to form sphingosine 1-phosphate (SPP), a lipid mediator with both intra- and extracellular functions. Also acts on D-erythro-sphingosine and to a lesser extent sphinganine, but not other lipids, such as D,L-threo-dihydrosphingosine, N,N-dimethylsphingosine, diacylglycerol, ceramide, or phosphatidylinositol. [UniProt] |
| Cellular Localization | Cytoplasm. Nucleus. Cell membrane. Note=Translocated from the cytoplasm to the plasma membrane in a CIB1-dependent manner |
| Calculated MW | 43 kDa |
Images (2) Click the Picture to Zoom In
-
ARG55846 anti-SPHK1 antibody IHC-P image
Immunohistochemistry: Paraffin-embedded Human kidney tissue stained with ARG55846 anti-SPHK1 antibody at 1:100 dilution.
-
ARG55846 anti-SPHK1 antibody WB image
Western blot: 35 µg of Human kidney lysate stained with ARG55846 anti-SPHK1 antibody at 1:1000 dilution.